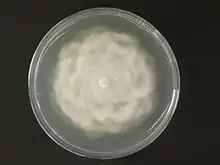

| Phytophthora cryptogea | |
|---|---|
| |
| P. cryptogea colony on potato dextrose agar | |
| Scientific classification | |
| Domain: | Eukaryota |
| Clade: | Diaphoretickes |
| Clade: | SAR |
| Clade: | Stramenopiles |
| Phylum: | Oomycota |
| Order: | Peronosporales |
| Family: | Peronosporaceae |
| Genus: | Phytophthora |
| Species: | P. cryptogea |
| Binomial name | |
| Phytophthora cryptogea Pethybr. & Laff., (1919) | |
Phytophthora cryptogea is a species of water mould in the family Pythiaceae. It is a plant pathogen that infects several species of cultivated plants, including over 40 species of cultivated flowers.[1] It was first described as the cause of tomato foot rot in tomatoes[2]
Host Range and Symptoms
This species is reported to be pathogenic on grandiflora petunia (Petunia × atkinsiana).[3] It causes root rot, shoot rot and shanking in tulips.[4] It also infects blue daze (Evolvulus glomeratus), dusty miller (Jacobaea maritima), Barberton daisy (Gerbera jamesonii), and garden verbena (Verbena × hybrida).[1] Like its relative Phytophtora cambivora, it can cause ink disease of chestnuts (Castanea sativa).[5]
The species is a cause of foot rot in tomatoes, causing discoloration and lesion in the stem. Progression of lesions leads to girdling, root system rot and plant collapse. Foliage will not be affected until plant stem has become girdled.[2]
Life Cycle
P. cryptogea are prolific in wet, waterlogged soil and can persist for long periods of time in soil on organic matter. It reproduces asexually through sporangiophores and accompanying non-papillate sporangia in liquid media as well as by uneven, irregular hyphal growth.[2] It does not produce chlamydospores.[2] Sexual reproduction is heterothallic, typically requiring an opposite mating type but sometimes occurring in aged single cultures.[2] Sexual structures produced are antheridia and oogonia that fill with oospores.[2]
Species Differentiation
This and Phytophthora drechsleri have been considered the same species, but phylogenetic analysis has revealed that they are two distinct species.[6]
References
- 1 2 Olson, H. A., et al. (2011). Phylogenetic history of Phytophthora cryptogea and P. drechsleri isolates from floriculture crops in North Carolina greenhouses. Phytopathology 101(11) 1373–84.
- 1 2 3 4 5 6 Ristaino, Jean Beagle (2016). "Phytophthora cryptogea". Identification of Common Phytophthora Species. Archived from the original on 20 February 2020. Retrieved 6 March 2023.
- ↑ Ampuero, J., et al. (2008). Identification of Phytophthora cryptogea as the cause of rapid decline of petunia (Petunia × hybrida) in Chile. Plant Disease 92(11) 1529–36.
- ↑ Buddin, W. (1938). Root rot, shoot rot and shanking of tulip caused by Phytophthora cryptogea Pethybr. & Laff. and P. erythro-septica Pethybr. Annals of Applied Biology 25(4) 705-29.
- ↑ Perlerou, C., et al. (2010). Phytophthora cryptogea causing ink disease of Castanea sativa newly reported in Greece. New Disease Reports 20 31.
- ↑ Mostowfizadeh-Ghalamfarsa, R., et al. (2010). Phylogenetic relationship of Phytophthora cryptogea Pethybr. & Laff and P. drechsleri Tucker. Fungal Biology 114(4) 325-39.
External links
- Phytophthora cryptogea. Index Fungorum.